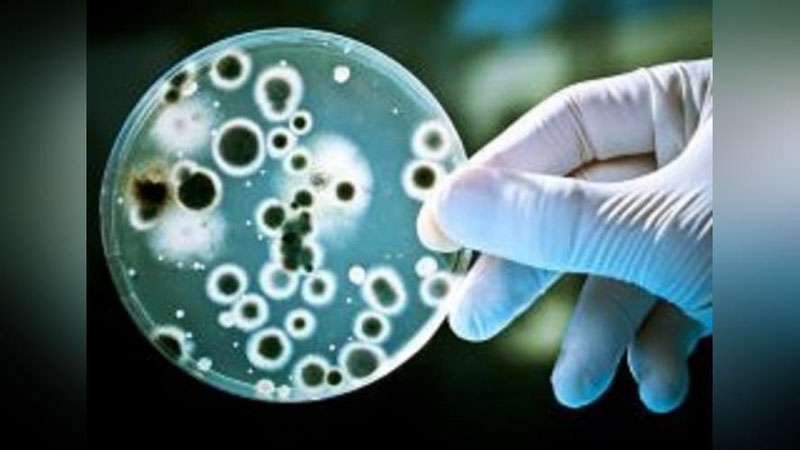
'JSST dunyoda xolera vabosi keng tarqalishidan xavotirda'ning rasmi

Jahon sog`liqni saqlash tashkiloti shu kunlarda insoniyat yana bir xavfli epidemiya bilan yuzlashishi ehtimolidan jiddiy tashvishda va bunga etarlicha asoslar ham bor.
Tashkilot bosh direktori Tedros Gebreesusning ta`kidlashicha, oxirgi bir yil ichida dunyoda xolera vabosiga chalinish holatlari keskin ko`paygan. Birgina joriy yilning o`tgan to`qqiz oyida 27 mamlakatda ushbu kasallik epidemiyasi kuzatilib, ko`plab bemorlar hayotdan ko`z yumgan.
Masalan, Suriyada so`nggi olti haftada 10 ming nafardan ortiq kishi mazkur xavfli infeksiyaga gumon qilingan.
Pokistonda esa 1 500 dan ortiq odamning hayotiga zomin bo`lgan dahshatli suv toshqinlaridan ko`p o`tmay xolera vabosi avj oldi. Agar shoshilinch choralar ko`rilmasa, yaqin haftalarda yana ko`plab odamlar xastalik qurboniga aylanishi mumkin.
"Xolera oqibatida bemorlar hatto bir necha soat ichida jon taslim qilishlari mumkin, — deydi JSST rahbari. — Shunga qaramay, zamonaviy tibbiyot maxsus muolajalar orqali xastalikni davolash imkoniyatiga ega. Kasallikka qarshi vaksinalar esa vabo profilaktikasida eng samarali chora.
Biroq dunyoning ba`zi mamlakatlari aholisi shundan ham bebahra. 2013 yilda hamkorlarimiz xoleraga qarshi vaksinalarning xalqaro zaxirasini yaratgandi. Ammo ular epidemiyaning oldini olish uchun etarli emas. Shu bois, bu borada shoshilinch choralar ko`rishimiz zarur".
Mutasaddining fikricha, jahonda bu yil turli epidemiyalar oqibatida sodir bo`layotgan o`lim holatlari besh yil avvalgi ko`rsatkichga nisbatan deyarli uch baravar oshganidan barchamiz to`g`ri xulosa chiqarishi zarur.
Eslatib o`tamiz, xolera vabosi ingichka ichakning zararlanishi, intoksikasiya, umumiy ahvol og`irlashuvi va organizm suvsizlanishi bilan kechadigan o`ta xavfli o`tkir infeksion kasallik hisoblanadi, deb xabar beradi Sog`liqni saqlash vazirligi matbuot xizmati.